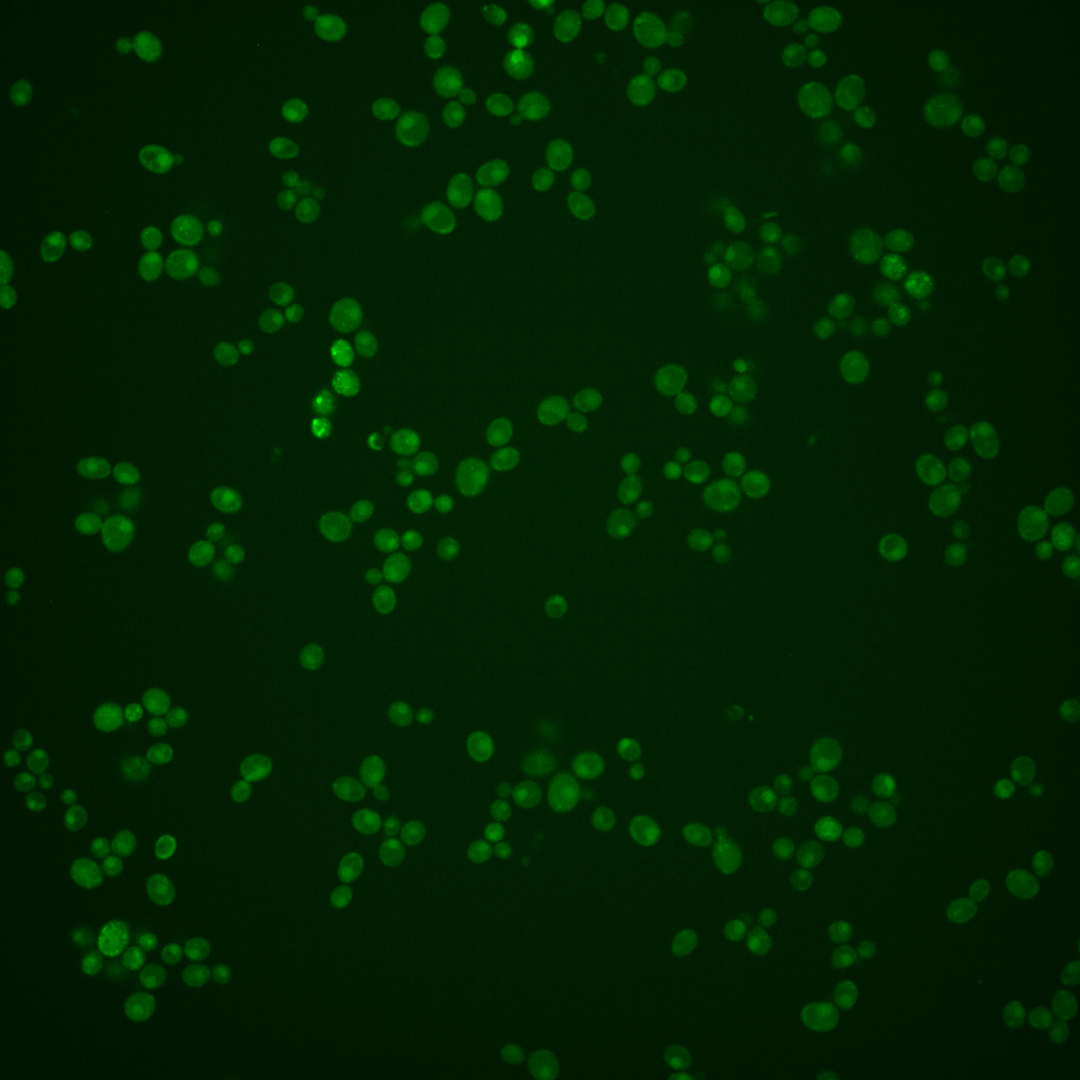

| Standard name | |
|---|---|
| Human Ortholog | |
| Description | Type II integral membrane protein; required for beta-1,6 glucan biosynthesis; putative beta-glucan synthase; localizes to ER, plasma membrane, sites of polarized growth and secretory vesicles; functionally redundant with Skn1p; KRE6 has a paralog, SKN1, that arose from the whole genome duplication |
Micrographs




















































































Sub-cellular Localization
Yeast GFP Assignment
Protein Abundance
Localization Change
External localization resources
| ensLOC | DeepLoc | |||||||||||||||||||||||
|---|---|---|---|---|---|---|---|---|---|---|---|---|---|---|---|---|---|---|---|---|---|---|---|---|
| Localization | WT1 | WT2 | WT3 | RAP60 | RAP140 | RAP220 | RAP300 | RAP380 | RAP460 | RAP540 | RAP620 | RAP700 | HU80 | HU120 | HU160 | rpd3Δ_1 | rpd3Δ_2 | rpd3Δ_3 | WT1 | WT2 | WT3 | AF100 | AF140 | AF180 |
| Cortical Patches | – | 0 | – | – | – | – | – | – | – | – | – | – | – | – | – | – | – | 0 | – | 0 | 0 | – | – | – |
| Bud | – | 1 | – | – | – | – | – | – | – | – | – | – | – | – | – | – | – | 0 | – | 0 | 0 | – | – | – |
| Bud Neck | – | 0 | – | – | – | – | – | – | – | – | – | – | – | – | – | – | – | 0 | – | 0 | 0 | – | – | – |
| Bud Site | – | 0 | – | – | – | – | – | – | – | – | – | – | – | – | – | – | – | 0 | – | – | – | – | – | – |
| Cell Periphery | – | 0 | – | – | – | – | – | – | – | – | – | – | – | – | – | – | – | 0 | – | 0 | 0 | – | – | – |
| Cytoplasm | – | 9 | – | – | – | – | – | – | – | – | – | – | – | – | – | – | – | 330 | – | 4 | 0 | – | – | – |
| Endoplasmic Reticulum | – | 1 | – | – | – | – | – | – | – | – | – | – | – | – | – | – | – | 23 | – | 0 | 0 | – | – | – |
| Endosome | – | 0 | – | – | – | – | – | – | – | – | – | – | – | – | – | – | – | 4 | – | 2 | 0 | – | – | – |
| Golgi | – | 0 | – | – | – | – | – | – | – | – | – | – | – | – | – | – | – | 2 | – | 0 | 0 | – | – | – |
| Mitochondria | – | 3 | – | – | – | – | – | – | – | – | – | – | – | – | – | – | – | 9 | – | 0 | 0 | – | – | – |
| Nucleus | – | 1 | – | – | – | – | – | – | – | – | – | – | – | – | – | – | – | 3 | – | 0 | 0 | – | – | – |
| Nuclear Periphery | – | 0 | – | – | – | – | – | – | – | – | – | – | – | – | – | – | – | 0 | – | 0 | 0 | – | – | – |
| Nucleolus | – | 0 | – | – | – | – | – | – | – | – | – | – | – | – | – | – | – | 0 | – | 0 | 0 | – | – | – |
| Peroxisomes | – | 0 | – | – | – | – | – | – | – | – | – | – | – | – | – | – | – | 0 | – | 0 | 0 | – | – | – |
| SpindlePole | – | 0 | – | – | – | – | – | – | – | – | – | – | – | – | – | – | – | 1 | – | 0 | 0 | – | – | – |
| Vac/Vac Membrane | – | 6 | – | – | – | – | – | – | – | – | – | – | – | – | – | – | – | 39 | – | 33 | 7 | – | – | – |
| Unique Cell Count | 19 | 364 | 48 | 10 | ||||||||||||||||||||
| Labelled Cell Count | 21 | 411 | 48 | 10 | ||||||||||||||||||||
Yeast GFP Assignment
Protein Abundance
| Screen | WT1 | WT2 | WT3 | RAP60 | RAP140 | RAP220 | RAP300 | RAP380 | RAP460 | RAP540 | RAP620 | RAP700 | HU80 | HU120 | HU160 | rpd3Δ_1 | rpd3Δ_2 | rpd3Δ_3 | AF100 | AF140 | AF180 |
|---|---|---|---|---|---|---|---|---|---|---|---|---|---|---|---|---|---|---|---|---|---|
| Mean Cell GFP Intensity (1e-4) | – | 5.2 | – | – | – | – | – | – | – | – | – | – | – | – | – | 3.8 | 4.3 | 5.1 | – | – | – |
| Std Deviation (1e-4) | – | 1.2 | – | – | – | – | – | – | – | – | – | – | – | – | – | 0.9 | 1.2 | 1.3 | – | – | – |
| Intensity Change (Log2) | – | – | – | – | – | – | – | – | – | – | – | – | – | – | – | – | – | – | – | – | – |
Localization Change
| Localization | RAP60 | RAP140 | RAP220 | RAP300 | RAP380 | RAP460 | RAP540 | RAP620 | RAP700 | HU80 | HU120 | HU160 | rpd3Δ_1 | rpd3Δ_2 | rpd3Δ_3 |
|---|---|---|---|---|---|---|---|---|---|---|---|---|---|---|---|
| Actin | – | – | – | – | – | – | – | – | – | – | – | – | – | – | – |
| Bud | – | – | – | – | – | – | – | – | – | – | – | – | – | – | – |
| Bud Neck | – | – | – | – | – | – | – | – | – | – | – | – | – | – | – |
| Bud Site | – | – | – | – | – | – | – | – | – | – | – | – | – | – | – |
| Cell Periphery | – | – | – | – | – | – | – | – | – | – | – | – | – | – | – |
| Cyto | – | – | – | – | – | – | – | – | – | – | – | – | – | – | – |
| Endoplasmic Reticulum | – | – | – | – | – | – | – | – | – | – | – | – | – | – | – |
| Endosome | – | – | – | – | – | – | – | – | – | – | – | – | – | – | – |
| Golgi | – | – | – | – | – | – | – | – | – | – | – | – | – | – | – |
| Mitochondria | – | – | – | – | – | – | – | – | – | – | – | – | – | – | – |
| Nuclear Periphery | – | – | – | – | – | – | – | – | – | – | – | – | – | – | – |
| Nuc | – | – | – | – | – | – | – | – | – | – | – | – | – | – | – |
| Nucleolus | – | – | – | – | – | – | – | – | – | – | – | – | – | – | – |
| Peroxisomes | – | – | – | – | – | – | – | – | – | – | – | – | – | – | – |
| SpindlePole | – | – | – | – | – | – | – | – | – | – | – | – | – | – | – |
| Vac | – | – | – | – | – | – | – | – | – | – | – | – | – | – | – |
| Cortical Patches | – | – | – | – | – | – | – | – | – | – | – | – | – | – | – |
| Cytoplasm | – | – | – | – | – | – | – | – | – | – | – | – | – | – | – |
| Nucleus | – | – | – | – | – | – | – | – | – | – | – | – | – | – | – |
| Vacuole | – | – | – | – | – | – | – | – | – | – | – | – | – | – | – |
External localization resources
Images






























Protein Concentration and Protein Localization Data
| R1 | R2 | R3 | ||||||||||||||||
|---|---|---|---|---|---|---|---|---|---|---|---|---|---|---|---|---|---|---|
| G1 Pre-START | G1 Post-START | S/G2 | Metaphase | Anaphase | Telophase | G1 Pre-START | G1 Post-START | S/G2 | Metaphase | Anaphase | Telophase | G1 Pre-START | G1 Post-START | S/G2 | Metaphase | Anaphase | Telophase | |
| Concentration | – | – | – | – | – | – | – | – | – | – | – | – | – | – | – | – | – | – |
| Actin | – | – | – | – | – | – | 0.2916 | 0.0027 | 0.001 | 0.0001 | 0.0007 | 0.0099 | 0.465 | 0.001 | 0.0003 | 0.0001 | 0.0001 | 0.0005 |
| Bud | – | – | – | – | – | – | 0.0031 | 0.0025 | 0.0044 | 0.007 | 0.0014 | 0.0005 | 0.0012 | 0.0029 | 0.004 | 0.0036 | 0.0014 | 0.0011 |
| Bud Neck | – | – | – | – | – | – | 0.21 | 0.0012 | 0.0062 | 0.0022 | 0.0014 | 0.006 | 0.007 | 0.0046 | 0.0082 | 0.0043 | 0.0029 | 0.0081 |
| Bud Periphery | – | – | – | – | – | – | 0.004 | 0.0045 | 0.0068 | 0.0034 | 0.0028 | 0.0008 | 0.0018 | 0.0043 | 0.0064 | 0.0049 | 0.002 | 0.0021 |
| Bud Site | – | – | – | – | – | – | 0.1041 | 0.0057 | 0.0054 | 0.004 | 0.002 | 0.0008 | 0.003 | 0.0069 | 0.0105 | 0.0111 | 0.0025 | 0.0017 |
| Cell Periphery | – | – | – | – | – | – | 0.0026 | 0.0009 | 0.001 | 0.0008 | 0.0006 | 0.0008 | 0.0003 | 0.0005 | 0.0009 | 0.0007 | 0.0005 | 0.0008 |
| Cytoplasm | – | – | – | – | – | – | 0.0252 | 0.2747 | 0.2687 | 0.1176 | 0.1459 | 0.3155 | 0.0747 | 0.3381 | 0.2869 | 0.1887 | 0.1092 | 0.332 |
| Cytoplasmic Foci | – | – | – | – | – | – | 0.0173 | 0.0366 | 0.0313 | 0.0448 | 0.0826 | 0.0389 | 0.0215 | 0.0505 | 0.0517 | 0.04 | 0.0361 | 0.0374 |
| Eisosomes | – | – | – | – | – | – | 0.0019 | 0.0001 | 0 | 0 | 0.0001 | 0.0017 | 0.0047 | 0 | 0 | 0 | 0 | 0 |
| Endoplasmic Reticulum | – | – | – | – | – | – | 0.0148 | 0.0093 | 0.0089 | 0.0053 | 0.0046 | 0.0045 | 0.0119 | 0.0061 | 0.0075 | 0.0046 | 0.0039 | 0.0059 |
| Endosome | – | – | – | – | – | – | 0.2188 | 0.1128 | 0.1433 | 0.2702 | 0.2549 | 0.1339 | 0.1158 | 0.0918 | 0.1222 | 0.1644 | 0.1663 | 0.095 |
| Golgi | – | – | – | – | – | – | 0.014 | 0.0018 | 0.0053 | 0.0031 | 0.006 | 0.0019 | 0.0417 | 0.002 | 0.0025 | 0.0022 | 0.002 | 0.0009 |
| Lipid Particles | – | – | – | – | – | – | 0.0039 | 0.003 | 0.0028 | 0.0034 | 0.0033 | 0.0012 | 0.0391 | 0.0017 | 0.0016 | 0.0011 | 0.002 | 0.0014 |
| Mitochondria | – | – | – | – | – | – | 0.0141 | 0.0023 | 0.0082 | 0.002 | 0.0468 | 0.001 | 0.0169 | 0.0044 | 0.0081 | 0.0037 | 0.0036 | 0.0012 |
| None | – | – | – | – | – | – | 0.002 | 0.3587 | 0.2204 | 0.1022 | 0.0544 | 0.1183 | 0.021 | 0.3566 | 0.2429 | 0.1684 | 0.1273 | 0.1188 |
| Nuclear Periphery | – | – | – | – | – | – | 0.0171 | 0.005 | 0.0045 | 0.0048 | 0.0031 | 0.0028 | 0.0119 | 0.0051 | 0.0059 | 0.0053 | 0.0057 | 0.0053 |
| Nucleolus | – | – | – | – | – | – | 0.0138 | 0.001 | 0.001 | 0.0015 | 0.001 | 0.0007 | 0.0026 | 0.0017 | 0.0025 | 0.0026 | 0.0023 | 0.0015 |
| Nucleus | – | – | – | – | – | – | 0.0061 | 0.0049 | 0.008 | 0.0064 | 0.0056 | 0.009 | 0.0416 | 0.0098 | 0.0156 | 0.0153 | 0.0125 | 0.0174 |
| Peroxisomes | – | – | – | – | – | – | 0.003 | 0.0004 | 0.0019 | 0.0008 | 0.0044 | 0.0004 | 0.0374 | 0.0009 | 0.0025 | 0.001 | 0.0019 | 0.0006 |
| Punctate Nuclear | – | – | – | – | – | – | 0.0056 | 0.0013 | 0.0005 | 0.0007 | 0.0014 | 0.0022 | 0.0043 | 0.0014 | 0.0019 | 0.0011 | 0.0063 | 0.0028 |
| Vacuole | – | – | – | – | – | – | 0.0154 | 0.1581 | 0.2522 | 0.3873 | 0.3473 | 0.3295 | 0.07 | 0.1007 | 0.1989 | 0.3515 | 0.4729 | 0.3463 |
| Vacuole Periphery | – | – | – | – | – | – | 0.0117 | 0.0124 | 0.0182 | 0.0326 | 0.0298 | 0.0196 | 0.0067 | 0.0091 | 0.019 | 0.0253 | 0.0385 | 0.0192 |
Sequencing Data
| R1 | R2 | |||||||||
|---|---|---|---|---|---|---|---|---|---|---|
| G1 Post-START | S/G2 | Metaphase | Anaphase | Telophase | G1 Post-START | S/G2 | Metaphase | Anaphase | Telophase | |
| Gene Expression | 190.5324 | 101.693 | 73.4302 | 84.1675 | 115.7453 | 128.9907 | 114.9251 | 96.9389 | 89.263 | 140.9201 |
| Translational Efficiency | 1.0148 | 1.1945 | 0.9012 | 0.7568 | 0.9747 | 1.352 | 0.9429 | 0.7598 | 0.7975 | 0.8253 |
Hit Data
| Dataset | Hit |
|---|---|
| Protein Concentration | – |
| Protein Localization | ✘ |
| Gene Expression | ✔ |
| Translational Efficiency | ✘ |
Endocytosis
| Temp | Actin Patch (Sac6-tdTomato) | Cortical Patch (Sla1-GFP) | Late Endosome (Snf7-GFP) | Vacuole (Vph1-GFP) |
|---|---|---|---|---|
| 37℃ | ||||
| RT |
Cell Cycle Omics
CYCLoPs (Kre6-GFP)
| Gene / Allele | Actin Patch (Sac6-tdTomato) | Cortical Patch (Sla1-GFP) | Late Endosome (Snf7-GFP) | Vacuole (Sac6-tdTomato) |
|---|
| Gene | Images |
|---|
| Gene | Images |
|---|
Images are not yet available
Images are not yet available